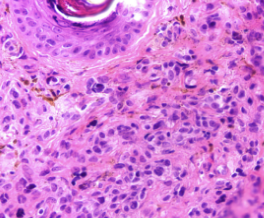

LABORATORIO ONELAB ESPECIALISTAS EN ANATOMÍA PATOLÓGICA EN EL DIAGNÓSTICO DE Servicio de Citología, Histopatología (tanto de rutina como especializada), Inmunohistoquimica, Biología molecular

Equipos de Vanguardia, Experiencia y atención personalizada

Que es la Anatomía Patológica?
Es la Ciencia que estudia las alteraciones fisiopatológicas y morfológicas de la enfermedad. Estudia la enfermedad a nivel orgánico, tisular, celular, subcelular, y molecular.